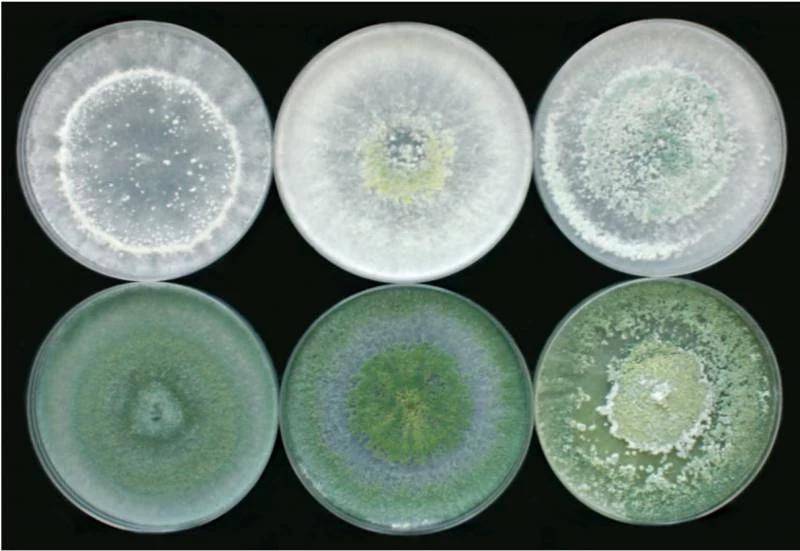

Польза йода для рассады, как использовать подкормку правильно

Йод – это не только антисептик, но и полезное удобрение для рассады. Он помогает растениям быстрее прорастать, укрепляет их иммунитет и защищает от ряда заболеваний. Применять йод можно как для полива, так и для опрыскивания листьев, что делает его универсальным средством для ухода за овощными культурами.
Полив рассады раствором йода
Полив с добавлением йода способствует быстрому росту рассады и повышает ее устойчивость к внешним неблагоприятным факторам, пишет сайт echonedeli.ru. Для приготовления раствора нужно:
- 1 капля йода;
- 3 литра воды.
Полученным раствором рассаду поливают под корень один раз за весь период роста. Такая подкормка особенно полезна для томатов, перца, огурцов, капусты и баклажанов.
Опрыскивание рассады йодом с молоком
Опрыскивание листьев йодом с молоком образует защитную пленку, которая предотвращает развитие грибковых и бактериальных заболеваний. Для приготовления раствора понадобятся:
- 4 литра воды;
- 1 литр молока (желательно домашнего, так как в нем сохраняется естественная микрофлора);
- 15 капель йода.
Все ингредиенты тщательно перемешивают и распыляют на листья с помощью мелкодисперсного опрыскивателя. Такой способ обработки помогает растениям лучше усваивать полезные вещества.
Преимущества использования йода для рассады
- Ускоряет рост растений;
- Повышает устойчивость к болезням;
- Стимулирует развитие корневой системы;
- Образует защитный барьер на листьях.
Применяя йодовые растворы для полива и опрыскивания рассады, можно значительно улучшить качество будущего урожая, снизить риск заболеваний и укрепить растения без применения химических удобрений.
Обсудим?
Смотрите также: